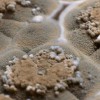

Mold issues can be very messy and usually involve musty odors that can be a headache to deal with. Although mold is abundant in nature and essential to life, it becomes a problem when in grows indoors. Mold spores become airborne which can then be inhaled and cause issues to an individuals respiratory system.
All-American Mold Remediation and Consulting
Luis Yanez —
They were helpful and stated they were willing to work within our budget.